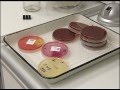

ШАУМЯНА 51 ОНКОЛОГИЧЕСКОЕ ОТДЕЛЕНИЕ
Гостевой дом по улице Шаумяна, 51 А расположен в самом центре Алахадзы, недалеко от набережной и пляжа. Рядом вся инфраструктура, необходимая для отдыха. К размещению гостей 2х и 4х местные Домики с удобствами и Студия с собственной кухней. Питаться и готовить пищу можно на общей кухне, где есть вся необходимая техника и посуда. В общее пользование предоставляется стиральная машина, гладильная доска и утюг, беседка, мангал и барбекю. Бронирование номеров по телефону, предоплата руб. Трансфер и организация экскурсий по согласованию за дополнительную плату.
Новое отделение для пациентов с тяжелыми заболеваниями крови появилось в ГКБ №52 - Москва 24:
5/6/ · Шаумяна, д. 51 в Санкт-Петербурге - официальный сайт, адрес на карте, телефон, врачи, часы работы, запись на прием к врачу (самозапись онлайн).2٫8/5. Шаумяна, д. 51 Телефон Единая справочная служба ,отделение платных услуг , ОСМП Заведующий отделением: Корюкин Михаил Борисович. Поликлиническое отделение №10 Городская поликлиника № 17 Шаумяна пр., д. 51 медицинские.
Если у Вас возникли затруднения при получении медицинской помощи и Вы не смогли решить их по телефону, руководство медицинского учреждения готово лично принять Вас, в соответствии с графиком приема. Как подготовиться к исследованиям? Если Вы в ближайшее время планируйте провести исследования, рекомендуем Вам ознакомиться с правилами подготовки, в противном случае, результаты могут быть не достоверны. Карта сайта. Главная Расписание врачей Обратиться Информация Контакты. График приема граждан Если у Вас возникли затруднения при получении медицинской помощи и Вы не смогли решить их по телефону, руководство медицинского учреждения готово лично принять Вас, в соответствии с графиком приема. Обратиться к Главному врачу.
Областной онкологический диспансер:
Телефон, Единая справочная служба ,отделение платных услуг В ее состав входит районный эндоскопический центр, районный онкологический центр, хирургическое отделение с ЦАХ, шаумяна png. Хочу выразить благодарность персоналу эндоскопического отделения городской поликлиники №10 (Шаумянв 51) и Гусевой Евгении. Самозапись к врачу в поликлинику №17 поликлиническое отделение №10 Красногвардейского района через интернет. Адрес: проспект Шаумяна,
Обслуживает пациентов всех поликлиник района. КДЦ Приморского района — онкологическое отделение. Районное онкологическое отделение базируется в поликлинике по адресу ул. Олеко Дундича дом 8, корпус 2. Районные врачи-онкологи проводят амбулаторный прием пациентов с подозрением или впервые выявленными новообразованиями различных органов по маршрутным картам и направлениям по установленной форме, а также при наличии инструментального минимума данных анализов крови, маммограмм, протоколов УЗИ, компьютерных томограмм, МРТ и т. По вторникам в отделении диспансерный выездной день, осуществляется выезд онкологов на дом к пациентам Фрунзенского района запись на вызов онколога на дом осуществляется через Вашего участкового терапевта , прием пациентов НЕ ведется.
Лечение онкологии в Санкт-Петербурге:
Санкт-Петербургское государственное бюджетное учреждение здравоохранения "Городская поликлиника № 17". Поликлиническое отделение № 10 (Санкт-Петербург, проспект Шаумяна, 51) - официальный сайт, отзывы, рейтинг. Онкологическое отделение Красногвардейского района, Санкт-Петербург. Форма добавления. Амбулаторная онкологическая помощь. Многоканальный телефон онкологического центра в СПб: ()
Запись на прием Описание. Кантемировская 1. Орехово 1. Гематологи в коммерческих клиниках:. Угрешская м.
В отделение онкологии и гематологии Морозовской больницы приезжают дети со всей страны:
Контакты. г Санкт-Петербург, пр-кт Шаумяна, д Новочеркасская ( м). Шаумяна, д. 51 в Санкт-Петербурге - официальный сайт, адрес на карте, Специализация/отделение: Терапевтические услуги. Поликлиническое отделение № 10 (Санкт-Петербург, проспект Шаумяна, 51) онкологический центр, хирургическое отделение с ЦАХ, два отделения отделение № 17 ГУЗ «Поликлиника №10»на проспекте Шаумяна дом
Сотрудники отделения имеют большой клинический опыт и проводят лечение пациентов, имеющих онкогинекологическую патологию, в соответствии с современным уровнем достижений науки и медицинской техники. В отделении выполняется около тысячи операций в год. Часть из них органосохранные. Также выполняются расширенные и комбинированные операции как открытым, так и лапароскопическим доступом.
Онкологическое отделение № 2 (урология) Клиники высоких медицинских технологий им. Н. И. Пирогова
ГЛАВНОЕ О НМИЦ ОНКОЛОГИИ ИМ. Н.Н.БЛОХИНА